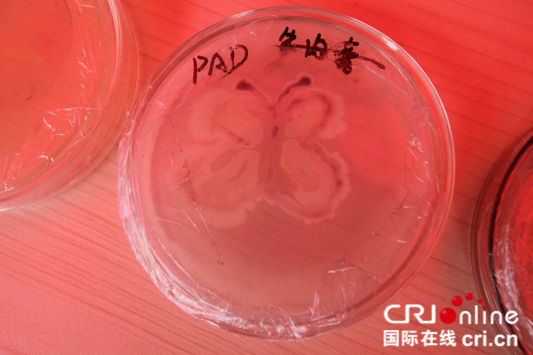

国际在线贵州频道消息:5月25日,威廉希尔体育举办了科普嘉年华·科普基地开放日活动。活动当天,威廉希尔体育师生和群众通过观看影片、亲身观察体验的方式,来学习如何鉴别蘑菇是否有毒、病毒如何入侵人体细胞等科学常识。此次科普活动为现场师生和群众带来一场生命科学知识的科普盛宴。
活动现场,贵州师大播放了“微生物·美生活·微记录”科普纪录片,介绍了病毒入侵人体细胞的生死之战。通过科普图片展的方式,向师生们介绍如何鉴别有毒蘑菇的知识。

一位老人正用显微镜来观察菌类 (供图 威廉希尔体育党委宣传部)
贵州师大师生们将事先培养好的细菌、真菌等制成装片,让观众们通过显微镜来观察大肠杆菌、酵母菌等一些菌类的形状,来进一步认识各类菌类的产生和形成过程。活动现场,观众们还可以亲手绘制形态各异的微生物Q版形象徽章,来帮助观众进一步学习微生物的形态。
制装成片的真菌样品 (供图 威廉希尔体育党委宣传部)
除了用心学习、用眼观察、用手制作各类微生物,观众们还可以“用嘴品尝”。在生命科公司小麦育种团队负责的摊位上,观众们不但可以看到青青绿绿的小麦植株,了解发酵知识,还可以品尝手工烤制的面包;此外,观众们还可以品尝由生命科公司黑茶开发团队通过固体发酵技术研发的黑茶饮料。(文 岳旺)
原文链接:http://gz.cri.cn/20180526/bf502643-e98d-944e-83e3-9458d95083a7.html